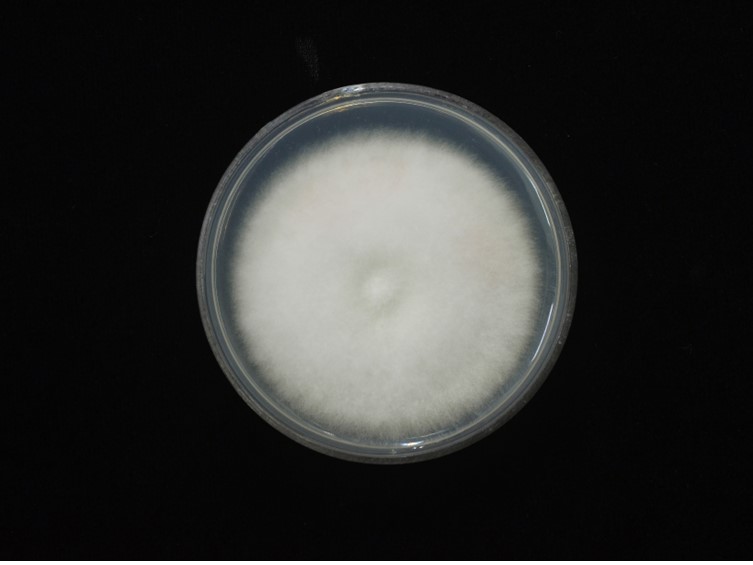

Holotype:
THAILAND, Phitsanulok Province, Ban Phaothai Community Forest, 25 Sep. 2015, K. Tasanathai, S. Mongkolsamrit, A. Khonsanit, W. Noisripoom, D. Thanakitpipattana, holotype BBH 42745, ex-type living culture BCC 79253.
Habitat:
Buried in soil.
Host:
Lepidopteran larva.
Description:
 Stromata solitary or multiple, 2.5-10 mm long and 0.5 mm broad, orange to reddish-orange, cylindrical
to enlarging apically. Rhizoids flexuous, arising from the head region of host larva buried in soil, 5-7 mm deep under the ground. Fertile part reddish orange, clavate, subglobose, 2-5 mm long, 1-1.5 mm broad.
Stromata solitary or multiple, 2.5-10 mm long and 0.5 mm broad, orange to reddish-orange, cylindrical
to enlarging apically. Rhizoids flexuous, arising from the head region of host larva buried in soil, 5-7 mm deep under the ground. Fertile part reddish orange, clavate, subglobose, 2-5 mm long, 1-1.5 mm broad.  Perithecia semi-immersed, ovoid, 250-350 × 130-200 μm.
Perithecia semi-immersed, ovoid, 250-350 × 130-200 μm.  Asci hyaline, cylindrical, 8-spored, 110-250 × 2- 5 μm. Ascospores hyaline, whole, bola-shaped, 150- 200 μm, central part filiform, 0.5 μm broad, terminal part narrowly fusiform, with septations, 40-75 × 1 μm. Anamorph: Conidial arrangement, evlachovaea-like.
Asci hyaline, cylindrical, 8-spored, 110-250 × 2- 5 μm. Ascospores hyaline, whole, bola-shaped, 150- 200 μm, central part filiform, 0.5 μm broad, terminal part narrowly fusiform, with septations, 40-75 × 1 μm. Anamorph: Conidial arrangement, evlachovaea-like.
Culture characteristics:
Colony on PDA attaining a diam of 30 mm in 10 d, cottony with high mycelium density, cream. Phialides arising from aerial hyphae, solitary or in whorls of two to three on each branch, swollen or cylindrical at the base tapering to the apex, 6–12 × 1.5–2 μm. Conidia hyaline, ovoid to fusiform, smooth, 3–4 × 1–2 μm.
Colony on PDA attaining a diam of 30 mm in 10 d, cottony with high mycelium density, cream. Phialides arising from aerial hyphae, solitary or in whorls of two to three on each branch, swollen or cylindrical at the base tapering to the apex, 6–12 × 1.5–2 μm. Conidia hyaline, ovoid to fusiform, smooth, 3–4 × 1–2 μm.
Reference:
Mongkolsamrit S, Noisripoom W, Tasanathai K, et al. (2020). Molecular phylogeny and morphology reveal cryptic species in Blackwellomyces and Cordyceps (Cordycipitaceae) from Thailand. Mycological Progress 19: 957–983.
DOI: https://doi.org/10.1007/s11557-020-01615-2Species |
Strain |
Compound |
Pubchem CID |
Biological activity |
Reference |
|---|
|
Strain |
ITS | LSU | RPB1 | RPB2 | TEF1 |
|---|---|---|---|---|---|
| BCC 78209 | - | MT003044 | MT017817 | MT017835 | MT017855 |
| BCC 79253 | MT000709 | MT003045 | - | MT017836 | MT017856 |